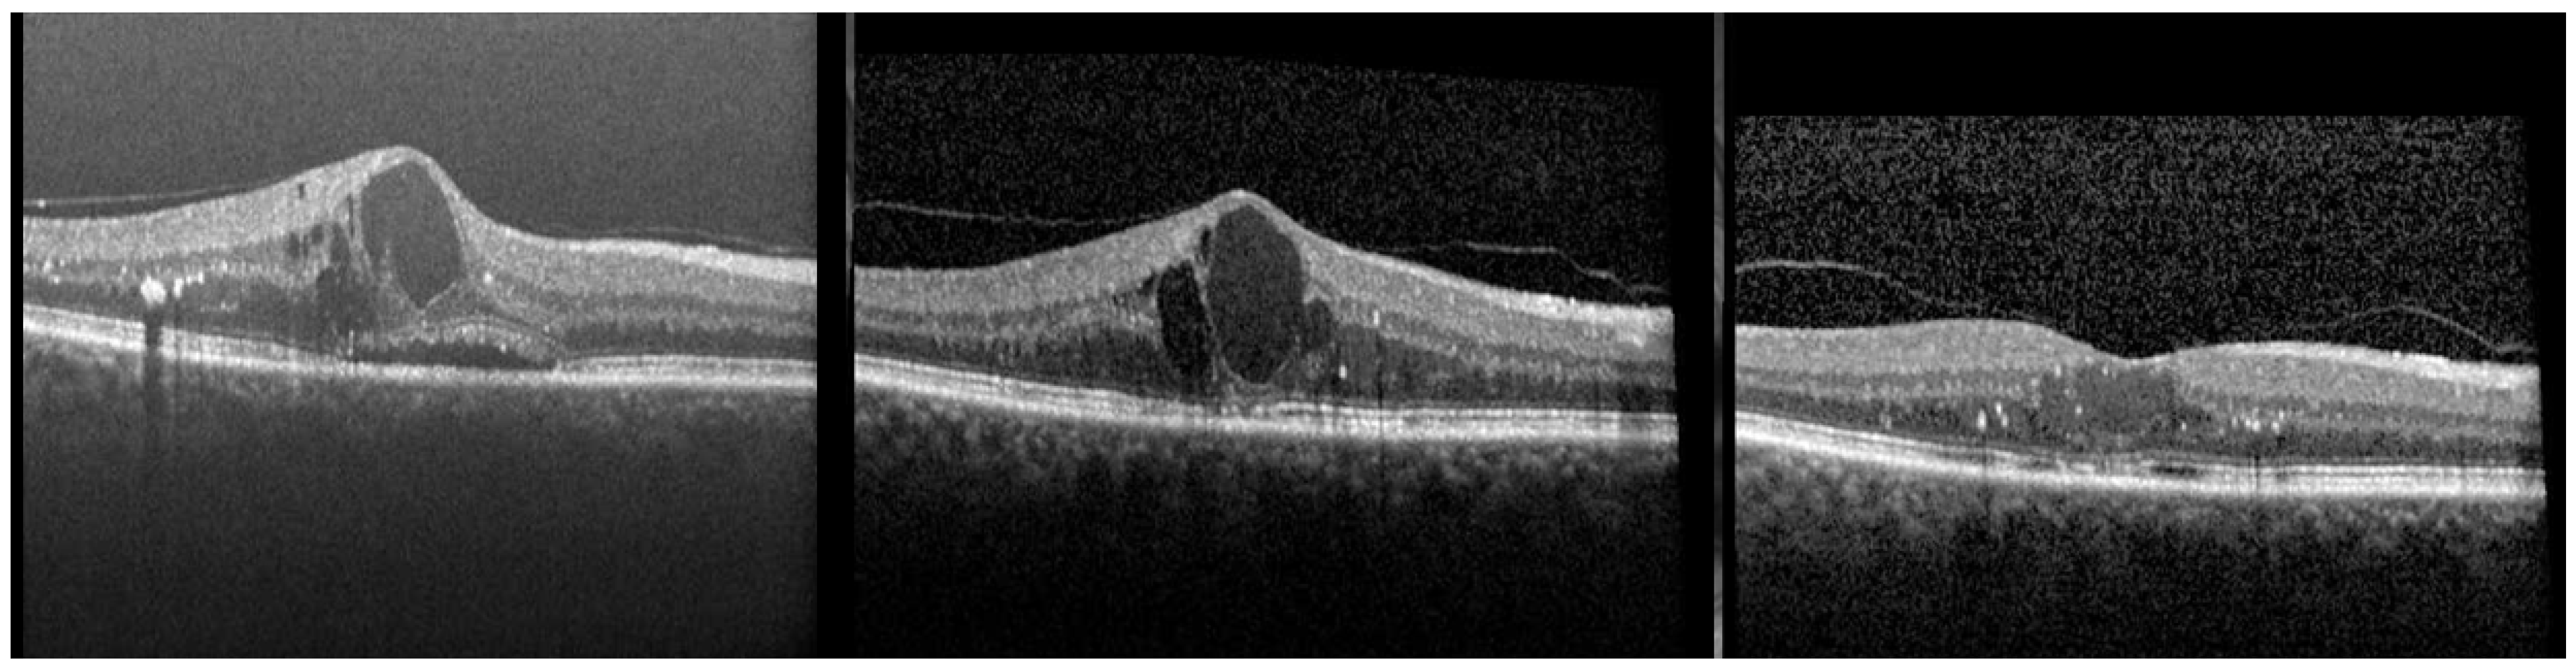
Ijms 23 07585 g001

The Role of Intravitreal Corticosteroids in the Treatment of DME: Predictive OCT Biomarkers
Abstract
1. Introduction
2. Method
3. General Considerations
4. Definition of Poor Response and Persistent DME
5. Inflammatory and Glycemic Biomarkers in Diabetic Retinopathy (DR) and DME
6. Aqueous Humor Biomarkers and Their Impact on Treatment Response
7. Morphological OCT Biomarkers in DME
7.1. Optical Coherence Tomography (OCT)
7.2. OCT Pattern of DME
7.3. Intraretinal Cysts
7.4. Central Subfield Retinal Thickness (CSMT)
7.5. Disorganization of the Retinal Inner Layers (DRIL)
7.6. Disorganization of Retinal Outer Layer (DROL)
7.7. Hyperreflective Foci (HRF)
7.8. Hyper-Reflective Cystoid Walls
7.9. Central Choroidal Thickness (CCT)
7.10. Vitreomacular Interface (VMI)
7.11. Subretinal Fluid (SRF)
8. Discussion and General Recommendation
Author Contributions
Funding
Institutional Review Board Statement
Informed Consent Statement
Data Availability Statement
Conflicts of Interest
Appendix A
| Biomarkers | Predictor of Good Response to Antivegf | Predictos of Good Response to Steroids | Candidate for First-Line Treatment with Steroids | Evidence * |
|---|---|---|---|---|
| INTRARETINAL CYSTS: -Large cysts ≥ 250 µm | NO | YES | YES | +++ |
| DRIL | NO | YES | YES | ++ |
| HRF | NO | YES | YES | +++ |
| HYPERREFLECTIVE CYSTOID WALLS | YES | NO | NO | + |
| VMA | YES | NO | NO | + |
| PVD | NO | YES | YES | + |
| SRF -acute DME | YES | NO | NO | +++ |
| SRF -chronic DME | NO | YES | YES | +++ |
| HIGH LEVELS OF VEGF IN AQUEOUS HUMOR | YES | NO | NO | ++ |
| HIGH LEVELS OF AQUEOUS OR SERUM: ICAM-1, MCP-1, IL6, IL8, IP-10, IL-1b | NO | YES | YES | +++ |
| Biomarker | References |
|---|---|
| Large Intraretinal Cysts | [68,69,70,71,72,73,74,75,76] |
| DRIL | [97,98,99] |
| HRF | [82,109,110,111,112,113,114,115,116,122] |
| SRF -acute DME | [23,146,147,150,151] |
| SRF -chronic DME | [22,98,115,152,154,177] |
| High Levels of Vegf in aqueous Humor | [35,48,123] |
| High Levels of Aqueous or Serum: ICAM-1, MCP-1, IL6, IL8, IP-10, IL-1b | [8,21,47,49,50,51,52,54] |
References
- Holekamp, N.M. Overview of diabetic macular edema. Am. J. Manag. Care 2016, 22, s284–s291. [Google Scholar]
- American Diabetes Association 2. Classification and Diagnosis of Diabetes. Diabetes Care 2016, 40, S11–S24. [Google Scholar] [CrossRef]
- Lee, R.; Wong, T.Y.; Sabanayagam, C. Epidemiology of diabetic retinopathy, diabetic macular edema and related vision loss. Eye Vis. 2015, 2, 17. [Google Scholar] [CrossRef] [PubMed]
- Boyer, D.S.; Hopkins, J.J.; Sorof, J.; Ehrlich, J.S. Anti-vascular endothelial growth factor therapy for diabetic macular edema. Ther. Adv. Endocrinol. Metab. 2013, 4, 151–169. [Google Scholar] [CrossRef] [PubMed]
- Treins, C.; Giorgetti-Peraldi, S.; Murdaca, J.; Van Obberghen, E. Regulation of Vascular Endothelial Growth Factor Expression by Advanced Glycation End Products. J. Biol. Chem. 2001, 276, 43836–43841. [Google Scholar] [CrossRef]
- Vinores, S.A.; Youssri, A.I.; Luna, J.D.; Chen, Y.S.; Bhargave, S.; Vinores, M.A.; Schoenfeld, C.L.; Peng, B.; Chan, C.C.; LaRochelle, W.; et al. Upregulation of vascular endothelial growth factor in ischemic and non-ischemic human and experimental retinal disease. Histol. Histopathol. 1997, 12, 99–109. [Google Scholar]
- Ascaso, F.J.; Huerva, V.; Grzybowski, A. The Role of Inflammation in the Pathogenesis of Macular Edema Secondary to Retinal Vascular Diseases. Mediat. Inflamm. 2014, 2014, 432685. [Google Scholar] [CrossRef]
- Funatsu, H.; Noma, H.; Mimura, T.; Eguchi, S.; Hori, S. Association of Vitreous Inflammatory Factors with Diabetic Macular Edema. Ophthalmology 2009, 116, 73–79. [Google Scholar] [CrossRef]
- Funk, M.; Schmidinger, G.; Maar, N.; Bolz, M.; Benesch, T.; Zlabinger, G.; Schmidt-Erfurth, U. Angiogenic and Inflammatory Markers in the Intraocular Fluid of Eyes with Diabetic Macular Edema and Influence of Therapy with Bevacizumab. Retina 2010, 30, 1412–1419. [Google Scholar] [CrossRef]
- Noma, H.; Mimura, T.; Yasuda, K.; Shimura, M. Role of Inflammation in Diabetic Macular Edema. Ophthalmologica 2014, 232, 127–135. [Google Scholar] [CrossRef]
- Owen, L.A.; Hartnett, M.E. Soluble Mediators of Diabetic Macular Edema: The Diagnostic Role of Aqueous VEGF and Cytokine Levels in Diabetic Macular Edema. Curr. Diabetes Rep. 2013, 13, 476–480. [Google Scholar] [CrossRef]
- Russo, A.; Costagliola, C.; Delcassi, L.; Parmeggiani, F.; Romano, M.R.; Dell’Omo, R.; Semeraro, F. Topical Nonsteroidal Anti-Inflammatory Drugs for Macular Edema. Mediat. Inflamm. 2013, 2013, 476525. [Google Scholar] [CrossRef]
- Scholl, S.; Kirchhof, J.; Augustin, A.J. Pathophysiology of macular edema. Ophthalmologica 2010, 224 (Suppl. 1), 8–15. [Google Scholar] [CrossRef]
- Brown, D.M.; Schmidt-Erfurth, U.; Do, D.V.; Holz, F.G.; Boyer, D.S.; Midena, E.; Heier, J.S.; Terasaki, H.; Kaiser, P.K.; Marcus, D.M.; et al. Intravitreal Aflibercept for Diabetic Macular Edema: 100-Week Results from the VISTA and VIVID Studies. Ophthalmology 2015, 122, 2044–2052. [Google Scholar] [CrossRef]
- Heier, J.S.; Korobelnik, J.F.; Brown, D.M.; Schmidt-Erfurth, U.; Do, D.V.; Midena, E.; Boyer, D.S.; Terasaki, H.; Kaiser, P.K.; Marcus, D.M.; et al. Intravitreal Aflibercept for Diabetic Macular Edema: 148-Week Results from the VISTA and VIVID Studies. Ophthalmology 2016, 123, 2376–2385. [Google Scholar] [CrossRef]
- Reddy, R.K.; Pieramici, D.J.; Gune, S.; Ghanekar, A.; Lu, N.; Quezada-Ruiz, C.; Baumal, C.R. Efficacy of Ranibizumab in Eyes with Diabetic Macular Edema and Macular Nonperfusion in RIDE and RISE. Ophthalmology 2018, 125, 1568–1574. [Google Scholar] [CrossRef]
- Wykoff, C.C.; Elman, M.J.; Regillo, C.D.; Ding, B.; Lu, N.; Stoilov, I. Predictors of Diabetic Macular Edema Treatment Frequency with Ranibizumab During the Open-Label Extension of the RIDE and RISE Trials. Ophthalmology 2016, 123, 1716–1721. [Google Scholar] [CrossRef]
- Cai, S.; Bressler, N.M. Aflibercept, bevacizumab or ranibizumab for diabetic macular oedema: Recent clinically relevant findings from DRCR.net Protocol T. Curr. Opin. Ophthalmol. 2017, 28, 636–643. [Google Scholar] [CrossRef]
- Bressler, N.M.; Beaulieu, W.T.; Glassman, A.R.; Blinder, K.J.; Bressler, S.B.; Jampol, L.M.; Melia, M.; Wells, J.A., III. Diabetic Retinopathy Clinical Research Network. Persistent Macular Thickening Following Intravitreous Aflibercept, Bevacizumab, or Ranibizumab for Central-Involved Diabetic Macular Edema With Vision Impairment: A Secondary Analysis of a Randomized Clinical Trial. JAMA Ophthalmol. 2018, 136, 257–269. [Google Scholar]
- Diabetes Control and Complications Trial Research Group. Early worsening of diabetic retinopathy in the Diabetes Control and Complications Trial. Arch. Ophthalmol. 1998, 116, 874–886. [Google Scholar] [CrossRef]
- Hillier, R.J.; Ojaimi, E.; Wong, D.T.; Mak, M.Y.K.; Berger, A.R.; Kohly, R.P.; Kertes, P.J.; Forooghian, F.; Boyd, S.R.; Eng, K.; et al. Aqueous humor cytokine levels as biomarkers of disease severity in diabetic macular edema. Retina 2017, 37, 761–769. [Google Scholar] [CrossRef]
- Abraham, J.R.; Wykoff, C.C.; Arepalli, S.; Lunasco, L.; Yu, H.J.; Hu, M.; Reese, J.; Srivastava, S.; Brown, D.M.; Ehlers, J.P. Aqueous Cytokine Expression and Higher Order OCT Biomarkers: Assessment of the Anatomic-Biologic Bridge in the IMAGINE DME Study. Am. J. Ophthalmol. 2020, 222, 328–339. [Google Scholar] [CrossRef]
- Sophie, R.L.; Campochiaro, N.P.A. Predictors of Functional and Anatomic Outcomes in Patients with Diabetic Macular Edema Treated with Ranibizumab. Ophthalmology 2015, 122, 1395–1401. [Google Scholar] [CrossRef] [PubMed]
- Gerendas, B.S.; Bogunovic, H.; Sadeghipour, A.; Schlegl, T.; Langs, G.; Waldstein, S.M.; Schmidt-Erfurth, U. Computational image analysis for prognosis determination in DME. Vis. Res. 2017, 139, 204–210. [Google Scholar] [CrossRef]
- Menon, K.; Pillai, G.; Xavier, T.; Pallikara, S.; Saji, N.; Radhakrishnan, N. Significance of monitoring vascular endothelial growth factor, monocyte chemoattractant protein-1 and Interleukin-8 in diabetic macular edema towards early identification of nonresponders to ranibizumab therapy. Indian J. Ophthalmol. 2021, 69, 1475–1481. [Google Scholar] [CrossRef] [PubMed]
- Schmidt-Erfurth, U.; Garcia-Arumi, J.; Bandello, F.; Berg, K.; Chakravarthy, U.; Gerendas, B.S.; Jonas, J.; Larsen, M.; Tadayoni, R.; Loewenstein, A. Guidelines for the Management of Diabetic Macular Edema by the European Society of Retina Specialists (EURETINA). Ophthalmologica 2017, 237, 185–222. [Google Scholar] [CrossRef]
- Korobelnik, J.-F.; Lu, C.; Katz, T.A.; Dhoot, D.S.; Loewenstein, A.; Arnold, J.; Staurenghi, G. Effect of Baseline Subretinal Fluid on Treatment Outcomes in VIVID-DME and VISTA-DME Studies. Ophthalmol. Retin. 2019, 3, 663–669. [Google Scholar] [CrossRef] [PubMed]
- Iglicki, M.; Busch, C.; Zur, D.; Okada, M.; Mariussi, M.; Chhablani, J.K.; Cebeci, Z.; Fraser-Bell, S.; Chaikitmongkol, V.; Couturier, A.; et al. Dexamethasone implant for diabetic macular edema in naive compared with re-fractory eyes: The international Retina Group Real-Life 24-Month Multicenter Study. The IRGREL-DEX Study. Retina 2019, 39, 44–51. [Google Scholar] [CrossRef] [PubMed]
- Khan, Z.; Kuriakose, R.K.; Khan, M.; Chin, E.K.; Almeida, D.R.P. Efficacy of the Intravitreal Sustained-Release Dexamethasone Implant for Diabetic Macular Edema Refractory to Anti-Vascular Endothelial Growth Factor Therapy: Meta-Analysis and Clinical Implications. Ophthalmic Surg. Lasers Imaging Retin. 2017, 48, 160–166. [Google Scholar] [CrossRef]
- Gonzalez, V.H.; Campbell, J.; Holekamp, N.M.; Kiss, S.; Loewenstein, A.; Augustin, A.J.; Ma, J.; Ho, A.C.; Patel, V.; Whitcup, S.M.; et al. Early and Long-Term Responses to Anti–Vascular Endothelial Growth Factor Therapy in Diabetic Macular Edema: Analysis of Protocol I Data. Am. J. Ophthalmol. 2016, 172, 72–79. [Google Scholar] [CrossRef]
- Song, J.; Chen, S.; Liu, X.; Duan, H.; Kong, J.; Li, Z. Relationship between C-reactive protein level and diabetic retinopathy: A systematic review and meta-analysis. PLoS ONE 2015, e0144406. [Google Scholar] [CrossRef]
- Kwan, C.C.; Fawzi, A.A. Imaging and Biomarkers in Diabetic Macular Edema and Diabetic Retinopathy. Curr. Diabetes Rep. 2019, 19, 95. [Google Scholar] [CrossRef]
- Vlassara, H.; Uribarri, J. Advanced Glycation End Products (AGE) and Diabetes: Cause, Effect, or Both? Curr. Diabetes Rep. 2014, 14, 453. [Google Scholar] [CrossRef]
- Hirata, K.; Kubo, K. Relationship between Blood Levels of N-Carboxymethyl-lysine and Pentosidine and the Severity of Microangiopathy in Type 2 Diabetes. Endocr. J. 2004, 51, 537–544. [Google Scholar] [CrossRef]
- Aiello, L.P.; Avery, R.L.; Arrigg, P.G.; Keyt, B.A.; Jampel, H.D.; Shah, S.T.; Pasquale, L.R.; Thieme, H.; Iwamoto, M.A.; Park, J.E.; et al. Vascular Endothelial Growth Factor in Ocular Fluid of Patients with Diabetic Retinopathy and Other Retinal Disorders. N. Engl. J. Med. 1994, 331, 1480–1487. [Google Scholar] [CrossRef]
- Yokota, T.; Ma, R.C.; Park, J.-Y.; Isshiki, K.; Sotiropoulos, K.B.; Rauniyar, R.K.; Bornfeldt, K.E.; King, G.L. Role of Protein Kinase C on the Expression of Platelet-Derived Growth Factor and Endothelin-1 in the Retina of Diabetic Rats and Cultured Retinal Capillary Pericytes. Diabetes 2003, 52, 838–845. [Google Scholar] [CrossRef]
- Dawson, D.W.; Volpert, O.V.; Gillis, P.; Crawford, S.E.; Xu, H.-J.; Benedict, W.; Bouck, N.P. Pigment Epithelium-Derived Factor: A Potent Inhibitor of Angiogenesis. Science 1999, 285, 245–248. [Google Scholar] [CrossRef]
- Davidović, S.; Babic, N.; Jovanović, S.; Barišić, S.; Grković, D.; Miljkovic, A. Serum erythropoietin concentration and its correlation with stage of diabetic retinopathy. BMC Ophthalmol. 2019, 19, 227. [Google Scholar] [CrossRef]
- Wang, Q.; Gorbey, S.; Pfister, F.; Höger, S.; Dorn-Beineke, A.; Krügel, K.; Berrone, E.; Wu, L.; Korff, T.; Lin, J.; et al. Long-term Treatment with Suberythropoietic Epo is Vaso- and Neuroprotective in Experimental Diabetic Retinopathy. Cell. Physiol. Biochem. 2011, 27, 769–782. [Google Scholar] [CrossRef]
- Mateos-Olivares, M.; García-Onrubia, L.; Valentín-Bravo, F.; González-Sarmiento, R.; Lopez-Galvez, M.; Pastor, J.; Usategui-Martín, R.; Pastor-Idoate, S. Rho-Kinase Inhibitors for the Treatment of Refractory Diabetic Macular Oedema. Cells 2021, 10, 1683. [Google Scholar] [CrossRef]
- Ahmadieh, H.; Nourinia, R.; Hafezi-Moghadam, A.; Sabbaghi, H.; Nakao, S.; Zandi, S.; Yaseri, M.; Tofighi, Z.; Akbarian, S. Intravitreal injection of a Rho-kinase inhibitor (fasudil) combined with bevacizumab versus bevaci-zumab monotherapy for diabetic macular oedema: A pilot randomised clinical trial. Br. J. Ophthalmol. 2019, 103, 922–927. [Google Scholar] [CrossRef]
- Yoshitake, T.; Murakami, T.; Yoshitake, S.; Suzuma, K.; Dodo, Y.; Fujimoto, M.; Ito, S.; Tsujikawa, A. Anti-Hexokinase 1 Antibody as a Novel Serum Biomarker of a Subgroup of Diabetic Macular Edema. Sci. Rep. 2019, 9, 4806. [Google Scholar] [CrossRef]
- Bluestone, J.A.; Herold, K.; Eisenbarth, G. Genetics, pathogenesis and clinical interventions in type 1 diabetes. Nature 2010, 464, 1293–1300. [Google Scholar] [CrossRef]
- Knip, M.; Veijola, R.; Virtanen, S.M.; Hyöty, H.; Vaarala, O.; Åkerblom, H.K. Environmental Triggers and Determinants of Type 1 Diabetes. Diabetes 2005, 54, S125–S136. [Google Scholar] [CrossRef]
- Vernino, S.; Low, P.A.; Fealey, R.D.; Stewart, J.D.; Farrugia, G.; Lennon, V.A. Autoantibodies to Ganglionic Acetylcholine Receptors in Autoimmune Autonomic Neuropathies. N. Engl. J. Med. 2000, 343, 847–855. [Google Scholar] [CrossRef]
- Das, A.; McGuire, P.G.; Rangasamy, S. Diabetic Macular Edema: Pathophysiology and Novel Therapeutic Targets. Ophthalmology 2015, 122, 1375–1394. [Google Scholar] [CrossRef]
- Vujosevic, S.; Micera, A.; Bini, S.; Berton, M.; Esposito, G.; Midena, E. Aqueous Humor Biomarkers of Müller Cell Activation in Diabetic Eyes. Investig. Opthalmology Vis. Sci. 2015, 56, 3913–3918. [Google Scholar] [CrossRef]
- Kwon, J.W.; Jee, D. Aqueous humor cytokine levels in patients with diabetic macular edema refractory to anti-VEGF treatment. PLoS ONE 2018, 13, e0203408. [Google Scholar]
- Zhang, X.; Zeng, H.; Bao, S.; Wang, N.; Gillies, M.C. Diabetic macular edema: New concepts in patho-physiology and treatment. Cell Biosci. 2014, 4, 27. [Google Scholar] [CrossRef]
- Simó, R.; Hernández, C. Novel approaches for treating diabetic retinopathy based on recent pathogenic evidence. Prog. Retin. Eye Res. 2015, 48, 160–180. [Google Scholar] [CrossRef]
- Sohn, H.J.; Han, D.H.; Kim, I.T.; Oh, I.K.; Kim, K.H.; Lee, D.Y.; Nam, D.H. Changes in Aqueous Concentrations of Various Cytokines After Intravitreal Triamcinolone Versus Bevacizumab for Diabetic Macular Edema. Am. J. Ophthalmol. 2011, 152, 686–694. [Google Scholar] [CrossRef] [PubMed]
- Podkowinski, D.; Orlowski-Wimmer, E.; Zlabinger, G.; Pollreisz, A.; Mursch-Edlmayr, A.; Mariacher, S.; Ring, M.; Bolz, M. Aqueous humour cytokine changes during a loading phase of intravitreal ranibizumab or dexame-thasone implant in diabetic macular oedema. Acta Ophthalmol. 2020, 98, e407–e415. [Google Scholar] [CrossRef] [PubMed]
- Tanaka, T.; Narazaki, M.; Kishimoto, T. IL-6 in inflammation, immunity, and disease. Cold Spring Harb. Perspect. Biol. 2014, 6, a016295. [Google Scholar] [CrossRef] [PubMed]
- Dong, N.; Xu, B.; Chu, L.; Tang, X. Study of 27 Aqueous Humor Cytokines in Type 2 Diabetic Patients with or without Macular Edema. PLoS ONE 2015, 10, e0125329. [Google Scholar] [CrossRef][Green Version]
- Choi, M.Y.; Jee, D.; Kwon, J.-W. Characteristics of diabetic macular edema patients refractory to anti-VEGF treatments and a dexamethasone implant. PLoS ONE 2019, 14, e0222364. [Google Scholar] [CrossRef]
- Udaondo, P.; Adan, A.; Arias-Barquet, L.; Ascaso, F.J.; Cabrera-López, F.; Castro-Navarro, V.; Donate-López, J.; García-Layana, A.; Lavid, F.J.; Rodríguez-Maqueda, M.; et al. Challenges in Diabetic Macular Edema Management: An Expert Consensus Report. Clin. Ophthalmol. 2021, 15, 3183–3195. [Google Scholar] [CrossRef]
- Kim, B.H.; Shin, J.Y.; Yu, H.G. Discrepancy in Fluorescein Angiography and Optical Coherence Tomography Findings of Macular Edema in Intermediate Uveitis. Ocul. Immunol. Inflamm. 2015, 24, 653–659. [Google Scholar] [CrossRef]
- Byeon, S.H.; Chu, Y.K.; Hong, Y.T.; Kim, M.; Kang, H.M.; Kwon, O.W. New insights into the pathoanatomy of diabetic macular edema: Angiographic patterns and optical coherence tomography. Retina 2012, 32, 1087–1099. [Google Scholar] [CrossRef]
- Koleva-Georgieva, D.N.; Sivkova, N.P. Types of diabetic macular edema assessed by optical coherence tomography. Folia Med. 2008, 50, 30–38. [Google Scholar]
- Panozzo, G.; Cicinelli, M.V.; Augustin, A.J.; Parodi, M.B.; Cunha-Vaz, J.; Guarnaccia, G.; Kodjikian, L.; Jampol, L.M.; Jünemann, A.; Lanzetta, P.; et al. An optical coherence tomography-based grading of diabetic maculopathy proposed by an international expert panel: The European School for Advanced Studies in Ophthalmology classification. Eur. J. Ophthalmol. 2019, 30, 8–18. [Google Scholar] [CrossRef]
- Negi, A.K.; Vernon, S.; Lim, C.S.; Owen-Armstrong, K. Intravitreal triamcinolone improves vision in eyes with chronic diabetic macular oedema refractory to laser photocoagulation. Eye 2004, 19, 747–751. [Google Scholar] [CrossRef]
- Jonas, J.B.; Martus, P.; Degenring, R.F.; Kreissig, I.; Akkoyun, I. Predictive Factors for Visual Acuity After Intravitreal Triamcinolone Treatment for Diabetic Macular Edema. Arch. Ophthalmol. 2005, 123, 1338–1343. [Google Scholar] [CrossRef]
- Khairallah, M.; Zeghidi, H.; Ladjimi, A.; BEN Yahia, S.; Attia, S.; Zaouali, S.; Messaoud, R. Primary intravitreal triamcinolone acetonide for diabetic massive macular hard exudates. Retina 2005, 25, 835–839. [Google Scholar] [CrossRef]
- Reznicek, L.; Bolz, M.; Garip, A.; Kampik, A.; Kernt, M.; Mayer, W.J. Evaluation of the New “SAVE” Protocol in Diabetic Macular Edema Over the Course of Anti-VEGF Treatment. Curr. Eye Res. 2015, 41, 1082–1086. [Google Scholar] [CrossRef]
- Chieh, J.J.L.; Martidis, A.M.; Roth, D.B.; Belmont, J.; Nelson, M.; Regillo, C.; Sivalingam, A.; Federman, J. Intravitreal Triamcinolone Acetonide for Diabetic Macular Edema. Retina 2005, 25, 828–834. [Google Scholar] [CrossRef]
- Martidis, A.; Duker, J.S.; Greenberg, P.B.; Rogers, A.H.; Puliafito, C.; Reichel, E.; Baumal, C. Intravitreal triamcinolone for refractory diabetic macular edema. Ophthalmology 2002, 109, 920–927. [Google Scholar] [CrossRef]
- Bolz, M.; Lammer, J.; Deak, G.; Pollreisz, A.; Mitsch, C.; Scholda, C.; Kundi, M.; Schmidt-Erfurth, U.; Diabetic Retinopathy Research Group Vienna. SAVE: A grading protocol for clinically significant diabetic macular oedema based on optical coherence tomography and fluorescein angiography. Br. J. Ophthalmol. 2014, 98, 1612–1617. [Google Scholar] [CrossRef]
- Battaglia, M.P.; Iacono, P.; Cascavilla, M.; Zucchiatti, I.; Bandello, F. A Pathogenetic Classification of Diabetic Macular Edema. Ophthalmic. Res. 2018, 60, 23–28. [Google Scholar]
- Dysli, M.; Rückert, R.; Munk, M.R. Differentiation of Underlying Pathologies of Macular Edema Using Spectral Domain Optical Coherence Tomography (SD-OCT). Ocul. Immunol. Inflamm. 2018, 27, 474–483. [Google Scholar] [CrossRef]
- Hecht, I.; Achiron, R.; Bar, A.; Munk, M.R.; Huf, W.; Burgansky-Eliash, Z.; Achiron, A. Development of “Predict ME”, an online classifier to aid in differentiating diabetic macular edema from pseudo-phakic macular edema. Eur. J. Ophthalmol. 2020, 30, 1495–1498. [Google Scholar] [CrossRef]
- Munk, M.R.; Jampol, L.M.; Simader, C.; Huf, W.; Mittermüller, T.J.; Jaffe, G.J.; Schmidt-Erfurth, U. Differentiation of Diabetic Macular Edema from Pseudophakic Cystoid Macular Edema by Spectral-Domain Optical Coherence Tomography. Investig. Ophthalmol. Vis. Sci. 2015, 56, 6724–6733. [Google Scholar] [CrossRef]
- Munk, M.R.; Sacu, S.; Huf, W.; Sulzbacher, F.; Mittermüller, T.J.; Eibenberger, K.; Rezar, S.; Bolz, M.; Kiss, C.G.; Simader, C.; et al. Differential diagnosis of macular edema of different pathophysiologic origins by spectral domain optical coherence tomography. Retina 2014, 34, 2218–2232. [Google Scholar] [CrossRef]
- Hecht, I.; Bar, A.; Rokach, L.; Achiron, R.N.; Munk, M.R.; Huf, W.; Burgansky-Eliash, Z.; Achiron, A. Optical coherence tomography biomarkers to distinguish diabetic macular edema from pseudophakic cystoid macular edema using machine learning algorithms. Retina 2019, 39, 2283–2291. [Google Scholar] [CrossRef]
- Munk, M.R.; Bolz, M.; Huf, W.; Sulzbacher, F.; Roberts, P.; Simader, C.; Rückert, R.; Kiss, C.G. Morphologic and functional evaluations during development, resolution, and relapse of uveitis-associated cystoid macular edema. Retina 2013, 33, 1673–1683. [Google Scholar] [CrossRef]
- Karst, S.G.; Lammer, J.; Mitsch, C.; Schober, M.; Mehta, J.; Scholda, C.; Kundi, M.; Kriechbaum, K.; Schmidt-Erfurth, U. Detailed analysis of retinal morphology in patients with diabetic macular edema (DME) randomized to ranibizumab or triamcinolone treatment. Graefes Arch. Clin. Exp. Ophthalmol. 2018, 256, 49–58. [Google Scholar] [CrossRef]
- Ceklic, L.; Huf, W.; Ebneter, A.; Wolf, S.; Zinkernagel, M.S.; Munk, M.R. The impact of ganglion cell layer cysts in diabetic macular oedema treated with anti-vascular endothelial growth factor. Acta Ophthalmol. 2019, 97, e1041–e1047. [Google Scholar] [CrossRef]
- Pelosini, L.; Hull, C.C.; Boyce, J.F.; McHugh, D.; Stanford, M.R.; Marshall, J. Optical Coherence Tomography May Be Used to Predict Visual Acuity in Patients with Macular Edema. Investig. Opthalmology Vis. Sci. 2011, 52, 2741–2748. [Google Scholar] [CrossRef] [PubMed]
- Hasegawa, N.; Nozaki, M.; Takase, N.; Yoshida, M.; Ogura, Y. New Insights Into Microaneurysms in the Deep Capillary Plexus Detected by Optical Coherence Tomography Angiography in Diabetic Macular Edema. Investig. Ophthalmol. Vis. Sci. 2016, 57, OCT348–OCT355. [Google Scholar] [CrossRef] [PubMed]
- Barthelmes, D.; Sutter, F.K.; Gillies, M.C. Differential optical densities of intraretinal spaces. Investig. Ophthalmol. Vis. Sci. 2008, 49, 3529–3534. [Google Scholar] [CrossRef]
- Reznicek, L.; Cserhati, S.; Seidensticker, F.; Liegl, R.; Kampik, A.; Ulbig, M.; Neubauer, A.S.; Kernt, M. Functional and morphological changes in diabetic macular edema over the course of anti-vascular endothelial growth factor treatment. Acta Ophthalmol. 2013, 91, e529–e536. [Google Scholar] [CrossRef] [PubMed]
- Karttunen, T.; Nummelin, L.; Kaarniranta, K.; Kinnunen, K. Real Life Experience of Dexamethasone Implant in Refractory Diabetic Macular Oedema. Clin. Ophthalmol. 2019, 13, 2583–2590. [Google Scholar] [CrossRef]
- Cao, J.; You, K.; Jin, K.; Lou, L.; Wang, Y.; Chen, M.; Pan, X.; Shao, J.; Su, Z.; Wu, J.; et al. Prediction of response to anti-vascular endothelial growth factor treatment in diabetic macular oedema using an optical coherence tomography-based machine learning method. Acta Ophthalmol. 2020, 99, e19–e27. [Google Scholar] [CrossRef]
- Meduri, A.; Oliverio, G.W.; Trombetta, L.; Giordano, M.; Inferrera, L.; Trombetta, C.J. Optical Coherence Tomography Predictors of Favorable Functional Response in Naïve Diabetic Macular Edema Eyes Treated with Dexamethasone Implants as a First-Line Agent. J. Ophthalmol. 2021, 2021, 1–5. [Google Scholar] [CrossRef]
- Wu, L.; Chawan-Saad, J.; Wu, M.; Wu, A. Corticosteroids for diabetic macular edema. Taiwan J. Ophthalmol. 2019, 9, 233–242. [Google Scholar] [CrossRef]
- Campochiaro, P.A.; Brown, D.M.; Pearson, A.; Ciulla, T.; Boyer, D.; Holz, F.G.; Tolentino, M.; Gupta, A.; Duarte, L.; Madreperla, S.; et al. Long-term Benefit of Sustained-Delivery Fluocinolone Acetonide Vitreous Inserts for Diabetic Macular Edema. Ophthalmology 2011, 118, 626–635.e2. [Google Scholar] [CrossRef]
- Early Treatment Diabetic Retinopathy Study Research Group. Treatment techniques and clinical guidelines for photocoagulation of diabetic macular edema. Early Treatment Diabetic Retinopathy Study Report Number 2. Ophthalmology 1987, 94, 761–774. [Google Scholar] [CrossRef]
- Pieramici, D.J.; Wang, P.-W.; Ding, B.; Gune, S. Visual and Anatomic Outcomes in Patients with Diabetic Macular Edema with Limited Initial Anatomic Response to Ranibizumab in RIDE and RISE. Ophthalmology 2016, 123, 1345–1350. [Google Scholar] [CrossRef]
- Deák, G.G.; Schmidt-Erfurth, U.; Jampol, L.M. Correlation of Central Retinal Thickness and Visual Acuity in Diabetic Macular Edema. JAMA Ophthalmol. 2018, 136, 1215–1216. [Google Scholar] [CrossRef]
- Diabetic Retinopathy Clinical Research Network; Browning, D.J.; Glassman, A.R.; Aiello, L.P.; Beck, R.W.; Brown, D.W.; Fong, D.S.; Bressler, N.M.; Danis, R.P. Relationship between optical coherence tomography-measured central retinal thickness and visual acuity in diabetic macular edema. Ophthalmology 2007, 114, 525–536. [Google Scholar]
- Santos, A.R.; Gomes, S.C.; Figueira, J.; Nunes, S.; Lobo, C.L.; Cunha-Vaz, J.G. Degree of Decrease in Central Retinal Thickness Predicts Visual Acuity Response to Intravitreal Ranibizumab in Diabetic Macular Edema. Ophthalmologica 2013, 231, 16–22. [Google Scholar] [CrossRef]
- Yalçın, G.; Baran Aksakal, F.N. Defining Cystoid Macular Degeneration in Diabetic Macular Edema: An OCT-Based Single-center Study. Turk. J. Ophthalmol. 2019, 49, 315–322. [Google Scholar] [CrossRef]
- Liang, Y.; Yan, B.; Meng, Z.; Xie, M.; Liang, Z.; Zhu, Z.; Meng, Y.; Ma, J.; Ma, B.; Yao, X.; et al. Comparison of Inflammatory and Angiogenic Factors in the Aqueous Humor of Vitrectomized and Non-Vitrectomized Eyes in Diabetic Macular Edema Patients. Front. Med. 2021, 8, 1466. [Google Scholar] [CrossRef]
- Jonas, J.B.; Jonas, R.; Neumaier, M.; Findeisen, P. Cytokine concentration in aqueous humor of eyes with diabetic macular edema. Retina 2012, 32, 2150–2157. [Google Scholar] [CrossRef]
- Sun, J.K.; Lin, M.M.; Lammer, J.; Prager, S.; Sarangi, R.; Silva, P.S.; Aiello, L.P. Disorganization of the Retinal Inner Layers as a Predictor of Visual Acuity in Eyes With Center-Involved Diabetic Macular Edema. JAMA Ophthalmol. 2014, 132, 1309–1316. [Google Scholar] [CrossRef]
- Castro-Navarro, V.; Monferrer-Adsuara, C.; Navarro-Palop, C.; Montero-Hernández, J.; Cervera-Taulet, E. Effect of dexamethasone intravitreal implant on visual acuity and foveal photoreceptor integrity in macular edema secondary to retinal vascular disease. Ophthalmologica 2020, 244, 83–92. [Google Scholar] [CrossRef]
- Chan, E.W.; Eldeeb, M.; Sun, V.; Thomas, D.; Omar, A.; Kapusta, M.A.; Galic, I.J.; Chen, J.C. Disorganization of Retinal Inner Layers and Ellipsoid Zone Disruption Predict Visual Outcomes in Central Retinal Vein Occlusion. Ophthalmol. Retin. 2018, 3, 83–92. [Google Scholar] [CrossRef]
- Hatz, K.; Ebneter, A.; Tuerksever, C.; Pruente, C.; Zinkernagel, M. Repeated Dexamethasone Intravitreal Implant for the Treatment of Diabetic Macular Oedema Unresponsive to Anti-VEGF Therapy: Outcome and Predictive SD-OCT Features. Ophthalmologica 2018, 239, 205–214. [Google Scholar] [CrossRef]
- Zur, D.; Iglicki, M.; Busch, C.; Invernizzi, A.; Mariussi, M.; Loewenstein, A.; Cebeci, Z.; Chhablani, J.K.; Chaikitmongkol, V.; Couturier, A.; et al. OCT Biomarkers as Functional Outcome Predictors in Diabetic Macular Edema Treated with Dexamethasone Implant. Ophthalmology 2018, 125, 267–275. [Google Scholar] [CrossRef] [PubMed]
- Udaondo, P. OCT and OCTA Biomarkers in Responder vs. Non-Responders to Anti-VEGF. In Proceedings of the 8th International Congress on OCT and OCT Angiography, Rome, Italy, 18–19 December 2020. [Google Scholar]
- Kessler, L.J.; Auffarth, G.U.; Bagautdinov, D.; Khoramnia, R. Ellipsoid Zone Integrity and Visual Acuity Changes during Diabetic Macular Edema Therapy: A Longitudinal Study. J. Diabetes Res. 2021, 2021, 8117650. [Google Scholar] [CrossRef] [PubMed]
- Scarinci, F.; Jampol, L.M.; Linsenmeier, R.A.; Fawzi, A.A. Association of Diabetic Macular Nonperfusion With Outer Retinal Disruption on Optical Coherence Tomography. JAMA Ophthalmol. 2015, 133, 1036–1044. [Google Scholar] [CrossRef] [PubMed]
- Muftuoglu, I.K.; Mendoza, N.; Gaber, R.; Alam, M.; You, Q.S.; Freeman, W.R. Integrity of outer retinal layers after resolution of central involved diabetic macular edema. Retina 2017, 37, 2015–2024. [Google Scholar] [CrossRef]
- Rangaraju, L.; Jiang, X.; McAnany, J.J.; Tan, M.R.; Wanek, J.; Blair, N.P.; Lim, J.I.; Shahidi, M. Association between Visual Acuity and Retinal Layer Metrics in Diabetics with and without Macular Edema. J. Ophthalmol. 2018, 2018, 1–8. [Google Scholar] [CrossRef]
- Lee, H.; Lee, J.; Chung, H.; Kim, H.C. Baseline spectral domain optical coherence tomographic hyperreflective foci as a predictor of visual outcome and recurrence for central serous chorioretinopathy. Retina 2016, 36, 1372–1380. [Google Scholar] [CrossRef]
- Altunel, O.; Duru, N.; Goktas, A.; Ozkose, A.; Goktas, E.; Atas, M. Evaluation of foveal photoreceptor layer in eyes with macular edema associated with branch retinal vein occlusion after ozurdex treatment. Int. Ophthalmol. 2016, 37, 333–339. [Google Scholar] [CrossRef]
- Bonfiglio, V.; Reibaldi, M.; Pizzo, A.; Russo, A.; Macchi, I.; Faro, G.; Avitabile, T.; Longo, A. Dexamethasone for unresponsive diabetic macular oedema: Optical coherence tomography biomarkers. Acta Ophthalmol. 2018, 97, e540–e544. [Google Scholar] [CrossRef]
- Iacono, P.; Parodi, M.B.; Scaramuzzi, M.; Bandello, F. Morphological and functional changes in recalcitrant diabetic macular oedema after intravitreal dexamethasone implant. Br. J. Ophthalmol. 2017, 101, 791–795. [Google Scholar] [CrossRef]
- Antonetti, D.A.; Klein, R.; Gardner, T.W. Diabetic retinopathy. N. Engl. J. Med. 2012, 366, 1227–1239. [Google Scholar] [CrossRef]
- Bolz, M.; Schmidt-Erfurth, U.; Deak, G.; Mylonas, G.; Kriechbaum, K.; Scholda, C. Optical Coherence Tomographic Hyperreflective Foci: A Morphologic Sign of Lipid Extravasation in Diabetic Macular Edema. Ophthalmology 2009, 116, 914–920. [Google Scholar] [CrossRef]
- Vujosevic, S.; Bini, S.; Midena, G.; Berton, M.; Pilotto, E.; Midena, E. Hyperreflective Intraretinal Spots in Diabetics without and with Nonproliferative Diabetic Retinopathy: An In Vivo Study Using Spectral Domain OCT. J. Diabetes Res. 2013, 2013, 1–5. [Google Scholar] [CrossRef]
- Roy, R.; Saurabh, K.; Shah, D.; Chowdhury, M.; Goel, S. Choroidal Hyperreflective Foci: A Novel Spectral Domain Optical Coherence Tomography Biomarker in Eyes With Diabetic Macular Edema. Asia-Pacific J. Ophthalmol. 2019, 8, 314–318. [Google Scholar] [CrossRef]
- Framme, C.; Schweizer, P.; Imesch, M.; Wolf, S.; Wolf-Schnurrbusch, U. Behavior of SD-OCT–Detected Hyperreflective Foci in the Retina of Anti-VEGF–Treated Patients with Diabetic Macular Edema. Investig. Opthalmology Vis. Sci. 2012, 53, 5814–5818. [Google Scholar] [CrossRef]
- Markan, A.; Agarwal, A.; Arora, A.; Bazgain, K.; Rana, V.; Gupta, V. Novel imaging biomarkers in diabetic retinopathy and diabetic macular edema. Ther. Adv. Ophthalmol. 2020, 12, 2515841420950513. [Google Scholar] [CrossRef]
- Mastropasqua, R.; D’Aloisio, R.; Di Nicola, M.; Di Martino, G.; Lamolinara, A.; Di Antonio, L.; Tognetto, D.; Toto, L. Relationship between aqueous humor cytokine level changes and retinal vascular changes after intravitreal aflibercept for diabetic macular edema. Sci. Rep. 2018, 8, 16548. [Google Scholar] [CrossRef]
- Horii, T.; Murakami, T.; Nishijima, K.; Akagi, T.; Uji, A.; Arakawa, N.; Muraoka, Y.; Yoshimura, N. Relationship between Fluorescein Pooling and Optical Coherence Tomographic Reflectivity of Cystoid Spaces in Diabetic Macular Edema. Ophthalmology 2012, 119, 1047–1055. [Google Scholar] [CrossRef]
- Terada, N.; Murakami, T.; Uji, A.; Dodo, Y.; Mori, Y.; Tsujikawa, A. Hyperreflective Walls in Foveal Cystoid Spaces as a Biomarker of Diabetic Macular Edema Refractory to Anti-VEGF Treatment. Sci. Rep. 2020, 10, 7299. [Google Scholar] [CrossRef]
- Liu, S.; Wang, D.; Chen, F.; Zhang, X. Hyperreflective foci in OCT image as a biomarker of poor prognosis in diabetic macular edema patients treating with Conbercept in China. BMC Ophthalmol. 2019, 19, 157. [Google Scholar] [CrossRef] [PubMed]
- Schreur, V.; de Breuk, A.; Venhuizen, F.G.; Sánchez, C.I.; Tack, C.J.; Klevering, B.J.; de Jong, E.K.; Hoyng, C.B. Retinal hyperreflective foci in type 1 diabetes mellitus. Retina 2020, 40, 1565–1573. [Google Scholar] [CrossRef] [PubMed]
- Ceravolo, I.; Oliverio, G.W.; Alibrandi, A.; Bhatti, A.; Trombetta, L.; Rejdak, R.; Toro, M.D.; Trombetta, C.J. The Application of Structural Retinal Biomarkers to Evaluate the Effect of Intravitreal Ranibizumab and Dexamethasone Intravitreal Implant on Treatment of Diabetic Macular Edema. Diagnostics 2020, 10, 413. [Google Scholar] [CrossRef] [PubMed]
- Arrigo, A.; Capone, L.; Lattanzio, R.; Aragona, E.; Zollet, P.; Bandello, F. Optical Coherence Tomography Biomarkers of Inflammation in Diabetic Macular Edema Treated by Fluocinolone Acetonide Intravitreal Drug-Delivery System Implant. Ophthalmol. Ther. 2020, 9, 971–980. [Google Scholar] [CrossRef] [PubMed]
- Ahn, J.; Han, S.; Ahn, S.M.; Kim, S.-W.; Oh, J. Clinical Implications of Suspended Scattering Particles in Motion Observed by Optical Coherence Tomography Angiography. Sci. Rep. 2020, 10, 15–19. [Google Scholar] [CrossRef]
- Kashani, A.H.; Green, K.M.; Kwon, J.; Chu, Z.; Zhang, Q.; Wang, R.K.; Garrity, S.; Sarraf, D.; Rebhun, C.B.; Waheed, N.K.; et al. Suspended Scattering Particles in Motion: A Novel Feature of OCT Angiography in Exudative Maculopathies. Ophthalmol. Retin. 2018, 2, 694–702. [Google Scholar] [CrossRef]
- Hillier, R.J.; Ojaimi, E.; Wong, D.T.; Mak, M.Y.K.; Berger, A.R.; Kohly, R.P.; Kertes, P.J.; Forooghian, F.; Boyd, S.R.; Eng, K.; et al. Aqueous Humor Cytokine Levels and Anatomic Response to Intravitreal Ranibizumab in Diabetic Macular Edema. JAMA Ophthalmol. 2018, 136, 382–388. [Google Scholar] [CrossRef]
- Mizutani, M.; Gerhardinger, C.; Lorenzi, M. Müller cell changes in human diabetic retinopathy. Diabetes 1998, 47, 445–449. [Google Scholar] [CrossRef]
- Wang, W.; Liu, S.; Qiu, Z.; He, M.; Wang, L.; Li, Y.; Huang, W. Choroidal Thickness in Diabetes and Diabetic Retinopathy: A Swept Source OCT Study. Investig. Opthalmology Vis. Sci. 2020, 61, 29. [Google Scholar] [CrossRef]
- Kim, J.T.; Lee, D.H.; Joe, S.G.; Kim, J.G.; Yoon, Y.H. Changes in choroidal thickness in relation to the severity of retinopathy and macular edema in type 2 diabetic patients. Investig. Ophthalmol. Vis. Sci. 2013, 54, 3378–3384. [Google Scholar] [CrossRef]
- Bressler, N.M.; Beck, R.W.; Ferris, F.L. Panretinal Photocoagulation for Proliferative Diabetic Retinopathy. N. Engl. J. Med. 2011, 365, 1520–1526. [Google Scholar] [CrossRef]
- Geyer, O.; Neudorfer, M.; Snir, T.; Goldstein, M.; Rock, T.; Silver, D.M.; Bartov, E. Pulsatile ocular blood flow in diabetic retinopathy. Acta Ophthalmol. Scand. 1999, 77, 522–525. [Google Scholar] [CrossRef]
- Kase, S.; Endo, H.; Takahashi, M.; Ito, Y.; Saito, M.; Yokoi, M.; Katsuta, S.; Sonoda, S.; Sakamoto, T.; Ishida, S.; et al. Alteration of choroidal vascular structure in diabetic macular edema. Graefe’s Arch. Clin. Exp. Ophthalmol. 2020, 258, 971–977. [Google Scholar] [CrossRef]
- Aksoy, M.; Yilmaz, G.; Vardarli, I.; Akkoyun, I. Choroidal Thickness After Dexamethasone Implant or Aflibercept in Patients with Diabetic Macular Edema Persistent to Ranibizumab. J. Ocul. Pharmacol. Ther. 2020, 36, 629–635. [Google Scholar] [CrossRef]
- Moon, K.Y.; Choi, S.Y.; Song, J.H. Changes in subfoveal choroidal thickness following intravitreal dexamethasone implant therapy for diabetic macular edema. Retina 2020, 41, 1283–1292. [Google Scholar] [CrossRef]
- Munk, M.R.; Ram, R.; Rademaker, A.; Liu, D.; Setlur, V.; Chau, F.; Schmidt-Erfurth, U.; Goldstein, D.A. Influence of the vitreomacular interface on the efficacy of intravitreal therapy for uveitis-associated cystoid macular oedema. Acta Ophthalmol. 2015, 93, e561–e567. [Google Scholar] [CrossRef] [PubMed]
- Munk, M.R.; Arendt, P.; Yu, S.; Ceklic, L.; Huf, W.; Ebneter, A.; Wolf, S.; Zinkernagel, M.S. The Impact of the Vitreomacular Interface in Neovascular Age-Related Macular Degeneration in a Treat-and-Extend Regimen with Exit Strategy. Ophthalmol. Retin. 2018, 2, 288–294. [Google Scholar] [CrossRef] [PubMed]
- Sadiq, M.A.; Soliman, M.; Sarwar, S.; Agarwal, A.; Hanout, M.; Demirel, S.; Rentiya, Z.S.; Khan, W.; Do, D.V.; Nguyen, Q.D.; et al. Effect of Vitreomacular Adhesion on Treatment Outcomes in the Ranibizumab for Edema of the Macula in Diabetes (READ-3) Study. Ophthalmology 2015, 123, 324–329. [Google Scholar] [CrossRef] [PubMed]
- Lee, H.; Jang, H.; Choi, Y.; Kim, H.C.; Chung, H. Association Between Soluble CD14 in the Aqueous Humor and Hyperreflective Foci on Optical Coherence Tomography in Patients With Diabetic Macular Edema. Investig. Opthalmology Vis. Sci. 2018, 59, 715–721. [Google Scholar] [CrossRef]
- Veloso, C.E.; Brocchi, D.N.; Singh, R.P.; Nehemy, M.B. Vitreomacular interface after anti-VEGF injections in diabetic macular edema. Int. J. Retin. Vitr. 2021, 7, 1–7. [Google Scholar] [CrossRef]
- Diabetic Retinopathy Clinical Research Network. Vitrectomy outcomes in eyes with diabetic macular edema and vitreomacular traction. Ophthalmology 2010, 117, 1087–1093.e3. [Google Scholar] [CrossRef]
- Amoaku, W.M.; Ghanchi, F.; Bailey, C.; Banerjee, S.; Banerjee, S.; Downey, L.; Gale, R.; Hamilton, R.; Khunti, K.; Posner, E.; et al. Diabetic retinopathy and diabetic macular oedema pathways and management: UK Consensus Working Group. Eye 2020, 34, 1–51. [Google Scholar] [CrossRef]
- Bressler, S.B.; Melia, M.; Glassman, A.R.; Almukhtar, T.; Jampol, L.M.; Shami, M.; Berger, B.B.; Bressler, N.M. Ranibizumab plus prompt or deferred laser for diabetic macular edema in eyes with vitrectomy before anti-vascular endothelial growth factor therapy. Retina 2015, 35, 2516–2528. [Google Scholar] [CrossRef]
- Gupta, A.; Raman, R.; Mohana, K.; Kulothungan, V.; Sharma, T. Communications between intraretinal and subretinal space on optical coherence tomography of neurosensory retinal detachment in diabetic macular edema. Oman J. Ophthalmol. 2013, 6, 183–188. [Google Scholar] [CrossRef]
- Eandi, C.M.; De Geronimo, D.; Giannini, D.; Polito, M.S.; Tosi, G.M.; Neri, G.; Le Mer, Y.; Varano, M.; Parravano, M. Baseline SD-OCT characteristics of diabetic macular oedema patterns can predict morphological features and timing of recurrence in patients treated with dexamethasone intravitreal implants. Geol. Rundsch. 2020, 57, 867–874. [Google Scholar] [CrossRef]
- Spaide, R.F. Retinal vascular cystoid macular edema: Review and new theory. Retina 2016, 36, 1823–1842. [Google Scholar] [CrossRef]
- Vujosevic, S.; Torresin, T.; Berton, M.; Bini, S.; Convento, E.; Midena, E. Diabetic Macular Edema With and Without Subfoveal Neuroretinal Detachment: Two Different Morphologic and Functional Entities. Am. J. Ophthalmol. 2017, 181, 149–155. [Google Scholar] [CrossRef]
- Kwon, J.-W.; Kim, B.; Jee, D.; Cho, Y.K. Aqueous humor analyses of diabetic macular edema patients with subretinal fluid. Sci. Rep. 2021, 11, 1–6. [Google Scholar] [CrossRef]
- Gaucher, D.; Sebah, C.; Erginay, A.; Haouchine, B.; Tadayoni, R.; Gaudric, A.; Massin, P. Optical Coherence Tomography Features During the Evolution of Serous Retinal Detachment in Patients with Diabetic Macular Edema. Am. J. Ophthalmol. 2008, 145, 289–296.e1. [Google Scholar] [CrossRef]
- Gerendas, B.S.; Prager, S.; Deak, G.; Simader, C.; Lammer, J.; Waldstein, S.M.; Guerin, T.; Kundi, M.; Schmidt-Erfurth, U. Predictive imaging biomarkers relevant for functional and anatomical outcomes during ranibizumab therapy of diabetic macular oedema. Br. J. Ophthalmol. 2017, 102, 195–203. [Google Scholar] [CrossRef]
- Fickweiler, W.; Schauwvlieghe, A.-S.M.E.; Schlingemann, R.O.; Hooymans, J.M.M.; Los, L.I.; Verbraak, F.D.; the BRDME Research Group. Predictive value of optical coherence tomographic features in the bevacizumab and ranibizumab in patients with diabetic macular edema (brdme) study. Retina 2018, 38, 812–819. [Google Scholar] [CrossRef]
- Gerendas, B.S.; Simader, C.; Deak, G.G.; Prager, S.G.; Lammer, J.; Waldstein, S.M.; Kundi, M.; Schmidt-Erfurth, U. Morphological parameters relevant for visual and anatomic outcomes during anti-VEGF therapy of diabetic macular edema in the RESTORE trial. Investig. Ophthalmol. Vis. Sci. 2014, 55, 1791. [Google Scholar]
- Sheu, S.-J.; Lee, Y.-Y.; Horng, Y.-H.; Lin, H.-S.; Lai, W.-Y.; Tsen, C.-L. Characteristics of diabetic macular edema on optical coherence tomography may change over time or after treatment. Clin. Ophthalmol. 2018, 12, 1887–1893. [Google Scholar] [CrossRef]
- Shimura, M.; Yasuda, K.; Yasuda, M.; Nakazawa, T. Visual outcome after intravitreal bevacizumab depends on the optical coherence tomographic patterns of patients with diffuse diabetic macular edema. Retina 2013, 33, 740–747. [Google Scholar] [CrossRef]
- Bin Hwang, H.; Jee, D.; Kwon, J.-W. Characteristics of diabetic macular edema patients with serous retinal detachment. Medicine 2019, 98, e18333. [Google Scholar] [CrossRef]
- Lee, H.; Kang, K.E.; Chung, H.; Kim, H.C. Prognostic Factors for Functional and Anatomic Outcomes in Patients with Diabetic Macular Edema Treated with Dexamethasone Implant. Korean J. Ophthalmol. 2018, 32, 116–125. [Google Scholar] [CrossRef][Green Version]
- Sonoda, S.; Sakamoto, T.; Shirasawa, M.; Yamashita, T.; Otsuka, H.; Terasaki, H. Correlation between Reflectivity of Subretinal Fluid in OCT Images and Concentration of Intravitreal VEGF in Eyes With Diabetic Macular Edema. Investig. Opthalmology Vis. Sci. 2013, 54, 5367–5374. [Google Scholar] [CrossRef]
- Liang, M.C.; Vora, R.A.; Duker, J.S.; Reichel, E. Solid-appearing retinal cysts in diabetic macular edema: A novel optical coherence tomography finding. Retin. Cases Brief Rep. 2013, 7, 255–258. [Google Scholar] [CrossRef]
- Wells, J.A.; Glassman, A.R.; Ayala, A.R.; Jampol, L.M.; Bressler, N.M.; Bressler, S.B.; Brucker, A.J.; Ferris, F.L.; Hampton, G.R.; Jhaveri, C.; et al. Aflibercept, Bevacizumab, or Ranibizumab for Diabetic Macular Edema: Two-Year Results from a Comparative Effectiveness Randomized Clinical Trial. Ophthalmology 2016, 123, 1351–1359. [Google Scholar] [CrossRef]
- Antcliff, R.J.; Hussain, A.A.; Marshall, J. Hydraulic conductivity of fixed retinal tissue after sequential excimer laser ablation: Barriers limiting fluid distribution and implications for cystoid macular edema. Arch. Ophthalmol. 2001, 119, 539–544. [Google Scholar] [CrossRef]
- Stewart, M.W. Corticosteroid use for diabetic macular edema: Old fad or new trend? Curr. Diabetes Rep. 2012, 12, 364–375. [Google Scholar] [CrossRef]
- Diabetic Retinopathy Clinical Research Network. A phase II randomized clinical trial of intravitreal bevacizumab for diabetic macular edema. Ophthalmology 2007, 114, 1860–1867. [Google Scholar] [CrossRef] [PubMed]
- Chhablani, J.; Wong, K.; Tan, G.S.; Sudhalkar, A.; Laude, A.; Cheung, C.M.G.; Zhao, P.; Uy, H.; Lim, J.; Valero, S.; et al. Diabetic Macular Edema Management in Asian Population: Expert Panel Consensus Guidelines. Asia-Pac. J. Ophthalmol. 2020, 9, 426–434. [Google Scholar] [CrossRef]
- Mehta, H.; Gillies, M.; Fraser-Bell, S. Perspective on the role of Ozurdex (dexamethasone intravitreal implant) in the man-agement of diabetic macular oedema. Ther. Adv. Chronic. Dis. 2015, 6, 234–245. [Google Scholar] [CrossRef]
- Pessoa, B.; Ferreira, A.; Leite, J.; Figueira, J.; Meireles, A.; Beirão, J.M. Optical Coherence Tomography Biomarkers: Vitreous Status Influence in Outcomes for Diabetic Macular Edema Therapy with 0.19-mg Fluocinolone Acetonide Implant. Ophthalmic Res. 2021, 64, 639–647. [Google Scholar] [CrossRef]
- Mathew, C.; Yunirakasiwi, A.; Sanjay, S. Updates in the Management of Diabetic Macular Edema. J. Diabetes Res. 2015, 2015, 794036. [Google Scholar] [CrossRef] [PubMed]
- Blinder, K.J.; Dugel, P.U.; Chen, S.; Jumper, J.M.; Walt, J.G.; Hollander, D.A.; Scott, L.C. Anti-VEGF treatment of diabetic macular edema in clinical practice: Effectiveness and patterns of use (ECHO Study Report 1). Clin. Ophthalmol. 2017, 11, 393–401. [Google Scholar] [CrossRef] [PubMed]
- Vujosevic, S.; Toma, C.; Villani, E.; Muraca, A.; Torti, E.; Florimbi, G.; Leporati, F.; Brambilla, M.; Nucci, P.; De Cilla’, S. Diabetic macular edema with neuroretinal detachment: OCT and OCT-angiography biomarkers of treatment response to anti-VEGF and steroids. Acta Diabetol. 2020, 57, 287–296. [Google Scholar] [CrossRef] [PubMed]
- Castro-Navarro, V.; Cervera-Taulet, E.; Navarro-Palop, C.; Monferrer-Adsuara, C.; Hernández-Bel, L.; Montero-Hernández, J. Intravitreal dexamethasone implant Ozurdex(R) in naive and refractory patients with different subtypes of diabetic macular edema. BMC Ophthalmol. 2019, 19, 15. [Google Scholar] [CrossRef]
- Urbančič, M.; Topčić, I.G. Dexamethasone implant in the management of diabetic macular edema from clinician’s perspective. Clin. Ophthalmol. 2019, 13, 829–840. [Google Scholar] [CrossRef]
- Tabakcı, B.N.; Ünlü, N. Corticosteroid Treatment in Diabetic Macular Edema. Turk. J. Ophthalmol. 2017, 47, 156–160. [Google Scholar] [CrossRef]
- Saleh, R.; Karpe, A.; Zinkernagel, M.S.; Munk, M.R. Inner retinal layer change in glaucoma patients receiving anti-VEGF for neovascular age related macular degeneration. Graefes Arch. Clin. Exp. Ophthalmol. 2017, 255, 817–824. [Google Scholar] [CrossRef]
- Vujosevic, S.; Simó, R. Local and Systemic Inflammatory Biomarkers of Diabetic Retinopathy: An Integrative Approach. Investig. Ophthalmol. Vis. Sci. 2017, 58, BIO68–BIO75. [Google Scholar] [CrossRef]
- Vujosevic, S.; Toma, C.; Nucci, P.; Brambilla, M.; De Cillà, S. Quantitative Color Fundus Autofluorescence in Patients with Diabetes Mellitus. J. Clin. Med. 2020, 10, 48. [Google Scholar] [CrossRef]
- Mota, S.E.H.-D.; Béjar-Cornejo, F.; Lima-Gómez, V.; Rodríguez-Ayala, E. Fundus autofluorescence in the evaluation of diabetic macular edema treatment response. Gac. Med. México 2022, 157, 397–403. [Google Scholar] [CrossRef]
- Filloy, A.; Chong, V.; Solé, E. Subthreshold yellow laser for fovea-involving diabetic macular edema in a series of patients with good vision: Effectiveness and safety of a fovea-sparing technique. BMC Ophthalmol. 2020, 20, 266. [Google Scholar] [CrossRef]
- Mota, S.H.-D.; Lima-Gómez, V.; Rodríguez-Ayala, E.; Fromow-Guerra, J.J.; Melo-Granados, E.A.R. Classification of fundus autofluorescence abnormal patterns in diabetic macular edema. Gac. Med. Mex. 2019, 155, 458–462. [Google Scholar] [CrossRef][Green Version]
- Saurabh, K.; Roy, R.; Goel, S. Correlation of multicolor images and conventional color fundus photographs with foveal autofluorescence patterns in diabetic macular edema. Indian J. Ophthalmol. 2020, 68, 141–144. [Google Scholar] [CrossRef]
- Yoshitake, S.; Murakami, T.; Uji, A.; Fujimoto, M.; Dodo, Y.; Suzuma, K.; Tsujikawa, A. Granular lesions of short-wavelength and near-infrared autofluorescence in diabetic macular oedema. Eye 2018, 33, 564–571. [Google Scholar] [CrossRef]
- Vujosevic, S.; Torresin, T.; Bini, S.; Convento, E.; Pilotto, E.; Parrozzani, R.; Midena, E. Imaging retinal inflammatory biomarkers after intravitreal steroid and anti-VEGF treatment in diabetic macular oedema. Acta Ophthalmol. 2017, 95, 464–471. [Google Scholar] [CrossRef]
- Imai, H.; Otsuka, K.; Tetsumoto, A.; Miki, A.; Nakamura, M. Effectivness of en bloc removal of fibrinogen-rich component of cystoid leasion for the treatment of cystoid macular edema. Retina 2020, 40, 154–159. [Google Scholar] [CrossRef]

Publisher’s Note: MDPI stays neutral with regard to jurisdictional claims in published maps and institutional affiliations. |
© 2022 by the authors. Licensee MDPI, Basel, Switzerland. This article is an open access article distributed under the terms and conditions of the Creative Commons Attribution (CC BY) license (https://creativecommons.org/licenses/by/4.0/).
Share and Cite
Munk, M.R.; Somfai, G.M.; de Smet, M.D.; Donati, G.; Menke, M.N.; Garweg, J.G.; Ceklic, L. The Role of Intravitreal Corticosteroids in the Treatment of DME: Predictive OCT Biomarkers. Int. J. Mol. Sci. 2022, 23, 7585. https://doi.org/10.3390/ijms23147585
Munk MR, Somfai GM, de Smet MD, Donati G, Menke MN, Garweg JG, Ceklic L. The Role of Intravitreal Corticosteroids in the Treatment of DME: Predictive OCT Biomarkers. International Journal of Molecular Sciences. 2022; 23(14):7585. https://doi.org/10.3390/ijms23147585
Chicago/Turabian StyleMunk, Marion R., Gabor Mark Somfai, Marc D. de Smet, Guy Donati, Marcel N. Menke, Justus G. Garweg, and Lala Ceklic. 2022. "The Role of Intravitreal Corticosteroids in the Treatment of DME: Predictive OCT Biomarkers" International Journal of Molecular Sciences 23, no. 14: 7585. https://doi.org/10.3390/ijms23147585
APA StyleMunk, M. R., Somfai, G. M., de Smet, M. D., Donati, G., Menke, M. N., Garweg, J. G., & Ceklic, L. (2022). The Role of Intravitreal Corticosteroids in the Treatment of DME: Predictive OCT Biomarkers. International Journal of Molecular Sciences, 23(14), 7585. https://doi.org/10.3390/ijms23147585

